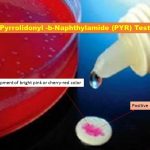
L-pyrrolidinyl-β-naphthylamide Test: Introduction, Principle, Procedure, Result Interpretation, Uses and Keynotes

Tag: procedure
Quellung Reaction: Introduction, Principle, Procedure, Result Interpretation, Uses and Keynotes
 Introduction of Quellung Reaction The quellung reaction is the swelling...
Introduction of Quellung Reaction The quellung reaction is the swelling...
Ascospore Agar: Introduction, Principle, Procedure, Colony Morphology, Uses and Keynotes
 Introduction of Ascospore Agar Ascospore Agar is recommended medium for...
Introduction of Ascospore Agar Ascospore Agar is recommended medium for...
L-pyrrolidinyl-β-naphthylamide Test: Introduction, Principle, Procedure, Result Interpretation, Uses and Keynotes
Uses of L-pyrrolidinyl-β-naphthylamide Test L-pyrrolidinyl-β-naphthylamide Test short form is PYR ...
Uses of L-pyrrolidinyl-β-naphthylamide Test L-pyrrolidinyl-β-naphthylamide Test short form is PYR ...
